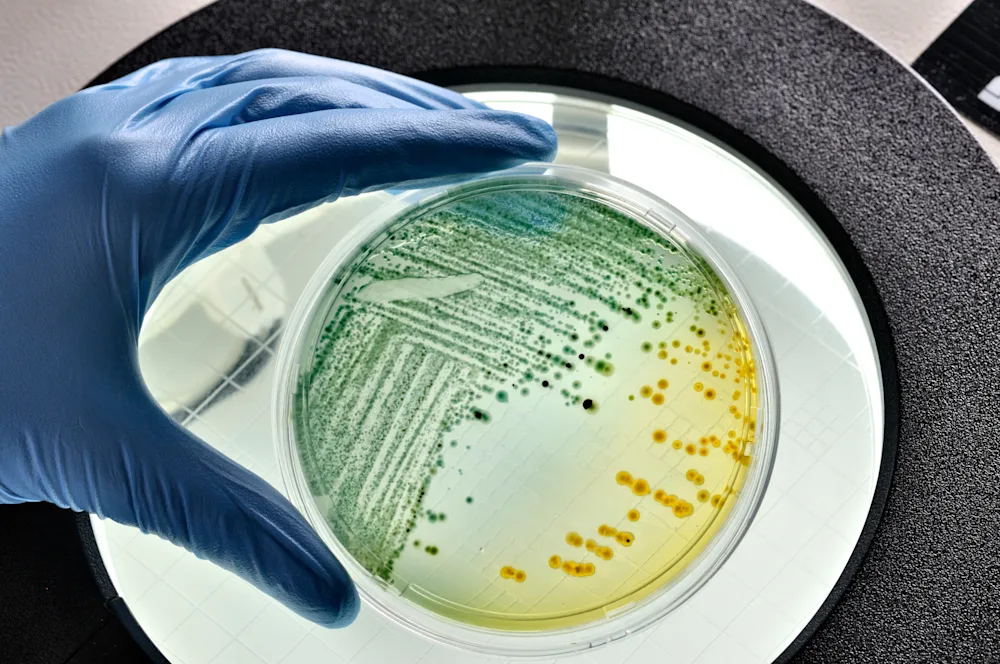

11. febrúar 2025
11. febrúar 2025
Þessi frétt er meira en árs gömul
Rannsókn stýrihóps á hópsýkingum tengdum þorrablótum
Föstudagskvöldið 31. janúar og laugardagskvöld 1. febrúar sl. voru haldin þorrablót á Borg í Grímsnesi og að Versölum í Þorlákshöfn. Í kjölfarið komu fram veikindi hjá fjölmörgum gestum. Bárust upplýsingar um veikindi hjá 67 gestum úr Grímsnesi og 73 frá Þorlákshöfn, samtals 140 einstaklingum, en mögulega hafa fleiri veikst. Einkenni voru fyrst og fremst niðurgangur og kviðverkir en hluti tilkynnti einnig um ógleði, uppköst og hita.
Rannsóknir á sýnum frá fólki og matvælum
Saursýni voru fengin frá nokkrum einstaklingum sem veiktust til að reyna að greina orsakavald og einnig voru tekin sýni til rannsókna úr matvælum sem voru á boðstólum á þorrablótunum. Bæði voru tekin sýni úr afgöngum og einnig úr matvælum sem enn voru í lokuðum, órofnum umbúðum frá framleiðanda.
Niðurstöður þessara rannsókna benda til þess að orsakavaldur sýkingarinnar geti verið svokallaður enteropathogenic E. coli (EPEC) og/eða Bacillus cereus bakteríur. Niðurstöður sýnatöku leiddu í ljós að svínasulta og sviðasulta af hlaðborðunum voru mengaðar af bakteríunni Bacillus cereus og svínasultan að auki af E. coli. Háar heildargerlatölur benda til þess að matvælin hafi staðið í töluverðan tíma án viðunandi kælingar, sem gefur bakteríunum færi á að fjölga sér.
Ályktanir af niðurstöðum rannsókna
Greining á sýnum úr sviðasultu og svínasultu úr órofnum umbúðum frá framleiðendum leiddi hins vegar í ljós að varan sjálf var án mengunar. Því virðist sem kælikeðja matvælanna hafi rofnað en með kælikeðju er átt við kerfi sem tryggir viðeigandi geymslu, flutning og meðhöndlun vara sem eru viðkvæmar fyrir hitabreytingum. Þessar niðurstöður benda til að meðferð matvælanna hafi verið ábótavant hjá veisluþjónustunni.
Í mörgum tilkynningum nefndi fólk að grunur beindist að kartöflum og uppstúfi sem orsakavaldi en ekki náðist að taka sýni af þeim matvælum þar sem afgangar voru ekki til staðar. Krosssmit getur orðið á milli matvæla og ekki liggur ljóst fyrir hvar gerlarnir áttu upptök sín.
E. coli og Bacillus cereus bakteríur
E. coli-stofn sem getur valdið iðrasýkingum greindist í þeim saursýnum sem fengust til rannsókna. Bacillus cereus getur myndað eitur í matvælunum og eitrið veldur einkennum matareitrunar, sé það innbyrt. Ekki er unnt að leita að eitrinu í saursýnunum og því ekki hægt að segja með vissu hver orsakavaldurinn er. Ekki greindist nóróveira í sýnunum. Að gefnu tilefni skal tekið fram að til eru margir mismunandi stofnar E. coli og er hér um annan stofn að ræða en þann sem greindist í hópsýkingu á leikskóla af völdum STEC (shiga-toxin myndandi E. coli) á síðasta ári.
Hlaðborð og meðhöndlun matvæla
Stýrihópur um rannsókn hópsýkingarinnar vill árétta að hlaðborðum fylgir áhætta. Algengar orsakir matarborinna sjúkdóma eru skortur á hreinlæti við meðferð matvæla og rangt hitastig sem getur orðið til þess að örverur ná sér á strik í matvælum. Heitur matur á að vera við 60 °C að lágmarki. Matvæli sem bera á fram kæld skal geyma í kæli (0-4 °C) þar til kemur að framreiðslu. Mikilvægt er að undirbúningsaðstaða sé fullnægjandi, að gott innra eftirlit sé til staðar og að handþvottaaðstaða sé viðunandi. Reglulega þarf að skipta um áhöld og ekki má endurnýta matvæli sem hafa verið frammi á borðum. Sjá nánar leiðbeiningar um hlaðborð á vef Matvælastofnunar.
Við fyrstu eftirlitsheimsókn Heilbrigðiseftirlits Suðurlands í Veisluþjónustu Suðurlands var alvarlegt frávik skráð þar sem starfsemin var án starfsleyfis. Einnig var aðstaða til handþvotta ófullnægjandi í eldhúsi. Heilbrigðiseftirlitið fór yfir verkferla með veisluþjónustunni og mun fylgja eftir að úrbætur verði gerðar.
Lokaskýrsla stýrihóps
Stýrihópur sóttvarnalæknis vinnur enn úr gögnum sem tengjast rannsókn málsins en lokaniðurstaða verður birt í skýrslu hópsins á næstunni.
Fyrir hönd stýrihóps um rannsókn á hópsýkingu,
Sóttvarnalæknir
Frekari upplýsingar
Matarsýkingar og matareitranir. Frétt 10. febrúar 2025
Matarbornar sýkingar og matareitranir. Embætti landlæknis - sóttvarnalæknir
Meðferð matvæla. Heilsuvera
Matarbornir sjúkdómar. Matvælastofnun
Promoting safe food handling. Alþjóðaheilbrigðismálastofnunin